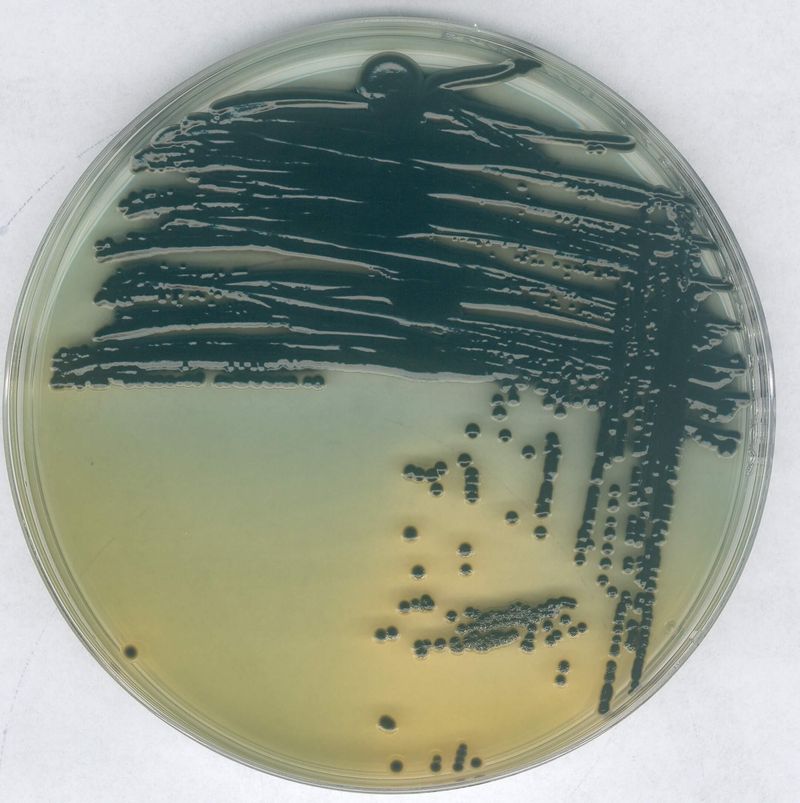

Características y ventajas
Características y ventajas
Dispense hasta 0,5 L de agua ultrapura por minuto a partir de agua purificadaContiene una lámpara UV de 185/254 nm incorporada para reducir el TOC a menos de 5 ppb.Auto mantenimiento simple y de bajo nivel.Agua de alta calidad para cumplir con los requisitos de su aplicación más crítica¡Depósito de agua pura integrado, no más bombonas!Los sistemas de purificación de agua Simplicity® UV tienen un depósito de agua pura integradoque le permite deshacerse de las engorrosas garrafas y la dudosa calidad del agua. Es fácil quitar eldepósito de 2 litros de su sistema UV Simplicity® y rellenarlo con una fuente de agua purapretratada, lo que hace que el sistema Simplicity® sea un sistema de purificación de agua perfectopara usar en laboratorios móviles.
Espacio de laboratorio optimizado
Diseñado para facilitar su trabajo, el tamaño reducido del sistema Simplicity® UV le permiteencontrar un espacio para él en cualquier parte de su laboratorio.Altas tasas de flujo ultrapuro para sus requisitosCon caudales superiores a 0,5 l/min, los sistemas de purificación de agua UV Simplicity®proporcionan agua ultrapura bajo demanda en los volúmenes necesarios para satisfacer lasaplicaciones críticas de laboratorio.
Mantenimiento fácil de usar
El cartucho de purificación SimpliPak® único tiene un diseño de encaje y desenganche que lepermite reemplazarlo en un par de minutos. Recibirá una notificación automática del sistemaSimplicity® cuando sea el momento de cambiar el cartucho.Sistema "nómada" compacto y portátilLos sistemas de purificación de agua Simplicity® UV producen agua ultrapura cuando la necesita,donde realmente la necesita: en la mesa de su laboratorio donde realiza sus experimentos. Elsistema no necesita instalación especial, ni conexión de agua de alimentación y produce aguaultrapura a partir de una variedad de tipos de agua pretratada, incluida agua de sistemas Elix® yagua destilada, desionizada o de ósmosis inversa (p. ej., sistemas RiOs™). El sistema de purificaciónde agua UV Simplicity® contiene una lámpara UV de doble longitud de onda para la fotooxidaciónde compuestos orgánicos.
Ajuste la calidad de su agua ultrapura
Un paso final de purificación en el punto de dispensación elimina contaminantes específicoscríticos para sus experimentos. Hay disponible una gama de cartuchos de purificación yApplication-Paks para ajustar el agua ultrapura según los requisitos.